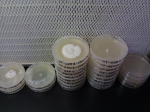

First select the desirable sized tub you will use. I'm using a 66qt for 10lbs of substrate.


Next you'll need to make holes for the polyfill. Select the desirable size circular saw.


Now you should use a ruler and marker to measure and mark where you want the holes. I made 2 on each side about 4.5" from the bottome and one on each end about 3" from the top...


Now that that's done, you need to start being as sterile as possible. Take a shower, wear clean clothes, face mask, and gloves. I used Lysol to disinfect the tub and rubbing alcohol for everything else that will be used including my hands...

Next you need to put in your liner (disinfected w/ Lysol) which is just a black plastic trashbag...

After you've done this, disinfect the outside of the bag containing your substrate w/ alcohol, then open and pour in w/o touching the sides of the tub. Once in (but after I disinfected my hands w/ alcohol) I broke up the clumps of substrate and "fluffed" it up (you don't want it to be compact) and evened it out...

When you're done doing that (clean your hands off under the sink, dry, then disinfect w/ alcohol) take your bag or jar of spawn and disinfect w/ alcohol then open and pour it out onto the substrate. Break spawn up into little bee-bee sized chunks and distribute evenly and mix well into the substrate like so...


Now you need to trim down your liner. Whatever you use to cut the excess liner off, be it scissors, exacto knife, etc... DISINFECT W/ ALCOHOL Then tape it to the inside of the tub like so...
Then tape it to the inside of the tub like so...


At this point you can use a ruler or level to even out the surface (make sure to disinfect!!) Then stuff the holes w/ the desirable amount of polyfill like so...

Put the lid on, then put the whole tub in a black trash bag and put it away somewhere warm to incubate. I put mine near the furnace b/c it gives off a lot of heat.



Next you'll need to make holes for the polyfill. Select the desirable size circular saw.


Now you should use a ruler and marker to measure and mark where you want the holes. I made 2 on each side about 4.5" from the bottome and one on each end about 3" from the top...


Now that that's done, you need to start being as sterile as possible. Take a shower, wear clean clothes, face mask, and gloves. I used Lysol to disinfect the tub and rubbing alcohol for everything else that will be used including my hands...

Next you need to put in your liner (disinfected w/ Lysol) which is just a black plastic trashbag...

After you've done this, disinfect the outside of the bag containing your substrate w/ alcohol, then open and pour in w/o touching the sides of the tub. Once in (but after I disinfected my hands w/ alcohol) I broke up the clumps of substrate and "fluffed" it up (you don't want it to be compact) and evened it out...

When you're done doing that (clean your hands off under the sink, dry, then disinfect w/ alcohol) take your bag or jar of spawn and disinfect w/ alcohol then open and pour it out onto the substrate. Break spawn up into little bee-bee sized chunks and distribute evenly and mix well into the substrate like so...


Now you need to trim down your liner. Whatever you use to cut the excess liner off, be it scissors, exacto knife, etc... DISINFECT W/ ALCOHOL
 Then tape it to the inside of the tub like so...
Then tape it to the inside of the tub like so...

At this point you can use a ruler or level to even out the surface (make sure to disinfect!!) Then stuff the holes w/ the desirable amount of polyfill like so...

Put the lid on, then put the whole tub in a black trash bag and put it away somewhere warm to incubate. I put mine near the furnace b/c it gives off a lot of heat.